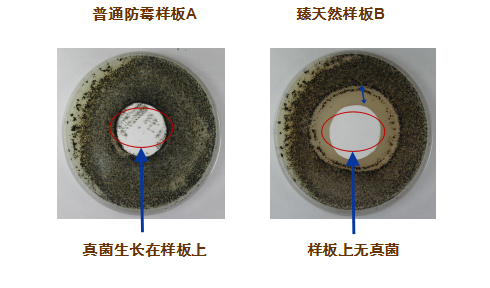
08.png

今年,隨著新冠病毒的瘋狂肆虐,疫情快速席卷全球多個國家和地區,成為當前全世界人類共同面臨的緊急重大公共衛生難題,其中關于室內空間健康問題也成為了人們的關注重點。
在疫情的嚴重影響下,無論是家居室內裝修,還是公共場所室內裝修,人們在選擇墻面涂料時,除了秉持以往的高環保標準和凈味需求,也更傾向于選擇那些具備抗病菌功效,能為室內空間健康提供更高保障的涂料產品。

作為擁有88載專業制漆經驗的實力企業,中華制漆堅持以客戶為中心,順勢推出長頸鹿牌臻天然抗病毒無機礦物涂料新品,滿足人們挑剔的涂料選購需求,用實力征服消費者,為更多場所的健康安全保駕護航!

長頸鹿牌臻天然抗病毒無機礦物涂料
抗病毒抗菌 雙重實力派
秉持一如既往的高品質生產標準,長頸鹿牌臻天然抗病毒無機礦物涂料由中華制漆技術團隊潛心研發,在原先的無機礦物涂料配方上再度升級,甄選環保天然材料,采用獨有的制漆工藝專利技術,反復調整制樣,層層把控生產、檢驗、出廠各個環節,全方位實現抗病毒抗菌功效的持久作用。

臻天然抗病毒無機礦物涂料獨有的科學配方中,各組分之間達到良好的相容性。在保證涂料氣味、質感及各種功效穩定的前提下,產品結合創新殺毒滅菌技術,快速破壞病菌核酸結構,使核酸物質變性,從而高效殺滅病菌,抑制病菌的滋生繁殖。在日后對墻面的防護中,產品也將持續發揮抗病菌功效,保持墻面持久清潔健康。
經國內權威微生物檢測機構分別對產品抗病毒性能和抗菌性能進行了嚴苛檢測,其實驗數據表明,臻天然抗病毒無機礦物涂料對甲型流感病毒(H3N2)、腸道病毒71型(引起手足口病的一種病毒)、大腸桿菌、金黃色葡萄球菌等病菌具有99.99%的超高滅活率,屬于可檢測的最高級別殺滅率,相較其它普通的裝修涂料,該產品擁有更穩定更出色的抗病菌功效。

*病毒滅活率達99.99%

*抗菌性能達到最高標準要求I級
抗病毒抗菌功效隨著墻面涂層的存在,不僅維持時間長,而且可針對生活中常見的多種病菌類型發揮作用。病菌在公共場所墻面存活時間久,加上大量繁殖蔓延,影響人們身體健康,選擇在家居及公共場所內墻涂裝中使用長頸鹿牌臻天然抗病毒無機礦物涂料,提升室內空間“免疫力”,無疑是對場所健康防護的更好選擇。

天然無機 低碳環保
長頸鹿牌臻天然抗病毒無機礦物涂料取材于天然無機礦物,不含有害物質,從原材料獲取、生產加工到使用的過程中,對環境不產生污染物質,其成膜擁有無機礦物涂料的天然氣味,對人體健康無危害,屬于不可多得的低碳環保、生態友好型墻面涂料。

防霉抗藻 性能卓越
在防霉抗藻性能方面,長頸鹿牌臻天然抗病毒無機礦物涂料的優異性遙遙領先于普通防霉涂料,符合0級防霉標準。憑借自身呈高堿性的無機礦物成分,霉菌在此條件下難以存活,加之所成漆膜擁有絕佳的透氣性,該產品無需添加化學抗菌劑和防霉劑,便具備天然的抵抗霉菌藻類生長的能力,達到對墻面防霉、防潮、防藻的更持久、更全面的防護效果。
防火抗燃 極耐高溫
臻天然抗病毒無機礦物涂料具有良好的防火抗燃性,可達到A級防火材料要求。在高溫灼燒下,能阻隔明火與基材的接觸并降低火災時有害物質的排放,相比于其他膠質涂料,具有更出色的防火抗燃表現,對人們的生命安全更有保障。

*燃燒性能等級為A級
耐久耐候 絕佳透氣
該產品涂刷于墻面后,將與墻體牢牢結合,形成堅硬飽滿、附著力強的漆膜涂層,新墻無需底漆也可輕易施工使用,具備超強的耐久耐候性。涂層中的微晶結構讓漆膜擁有絕佳的透氣性能,充分吸收墻面水分,即便在潮濕多雨的季節,也能保持墻體干燥,讓人們暢享潔凈、舒適的生活環境。

長頸鹿牌臻天然抗病毒無機礦物涂料不僅通過國家權威檢驗機構專業檢驗,在性能、安全及抗病菌防霉等多個項目的檢驗結果均超行業標準,同時取得中國環境標志產品十環認證標志,屬于質量優異、綠色環保產品。憑借自身擁有的多方面性能優勢,長頸鹿牌臻天然抗病毒無機礦物涂料不僅適用于家居墻面涂裝,還可在酒店、餐廳、學校、醫院、超市、地下車庫等眾多公共場所中充分使用。

長頸鹿牌臻天然抗病毒無機礦物涂料的強勢出道,是中華制漆在技術和產品上的再一次創新。即便在疫情影響下,公司也將繼續堅持以市場為導向,以客戶為中心,不斷提高技術創新能力和產品質量,持續為建筑空間注入健康生命力,為客戶提供更優質的產品和服務,創造更具價值的全場景涂裝解決方案。

 分享好友
分享好友



